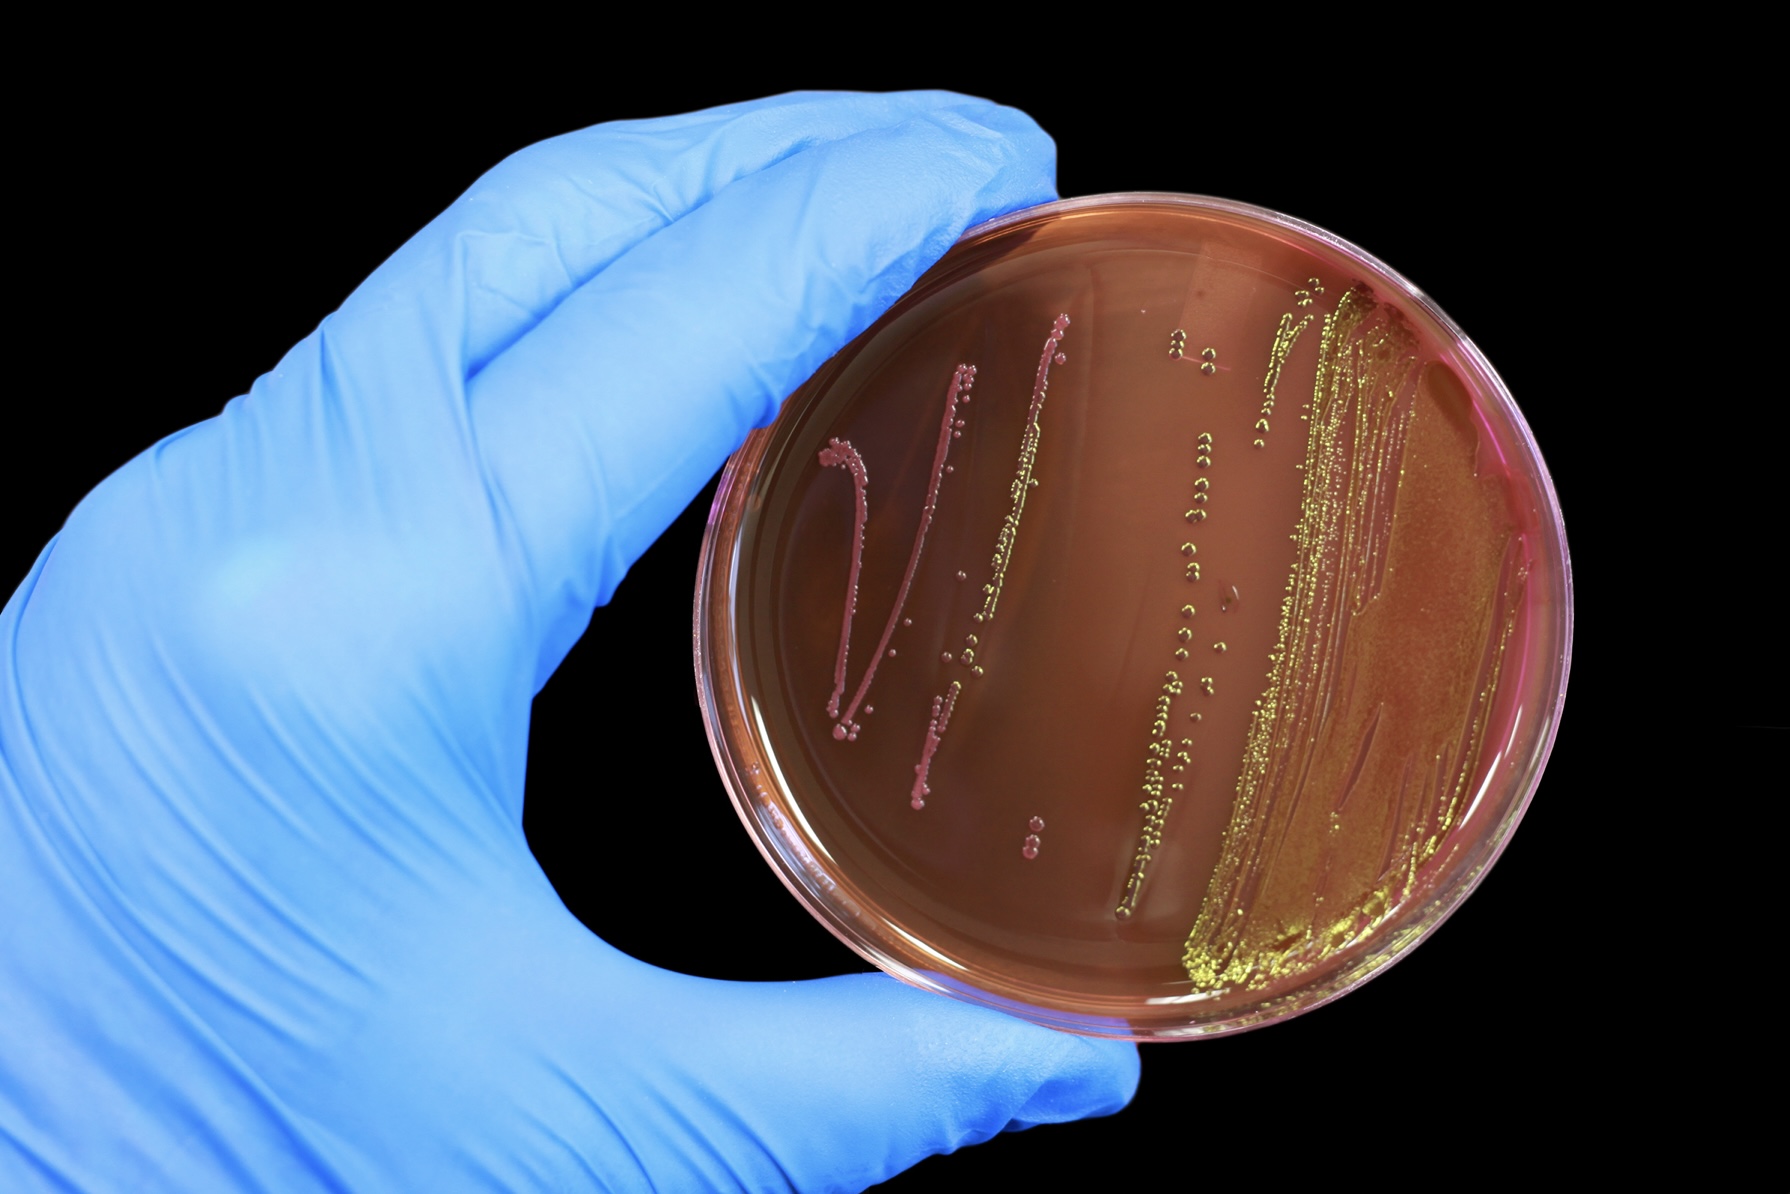

Nýggja kanningin bendir á, at mótstøðu- og fjølmótstøðuførar bakteriur og mótstøðuførar ílegur, sum stava frá frárenslum úr rottangum og kloakkum, dálka rættiliga víða um í Havn.
- Ja, vit hava funnið fleiri keðiligar bakteriur og ílegur bæði á sjógvi og landi, sum kunnu vera heilsuskaðiligar, sigur Anni Djurhuus, lektari á Náttúruvísindadeildini á Fróðskaparsetri Føroya.
Anni Djurhuus hevur saman við Annu Mariu Steintún Mortensen, Sissal Jóhannu Poulsen og Marjuni á Fríðriksmørk Berbisá, í fleiri umførum kannað støðuna Yviri við Strond beint niðan fyri Betri Banka, og niðan fyri Sjósavnið á Argjum.
Tær tóku sýnir úr hyljum á landi, í sjónum og úr reinsubrunnunum sjálvum. Á Skansanum tóku tær sýnir av vatninum, sum rennur inn í reinsibrunnin, og av vatninum, sum rennur út úr honum. Eisini vórðu royndir gjørdar av vatninum í Havnará og av frárenslinum frá ánni, sum rennur nærum ótarnað beint á sjógv, tó við onkrum smærri rottangum longri uppi.
Í stuttum staðfestir kanningin lutfalsliga víða dálking frá frárensli úr rottangum og kloakkum út í umhvørvið. Og at talan er um mótstøðuførar og fjølmótstøðuførar bakteriur, umframt mótstøðurførar ílegur.
- Kloakkir renna út á sjógv fleiri staðni í bygdum og býum í Føroyum. Vit vita sera lítið um ávirkanina av hesum, men okkara fyrstu tøl benda á, at hetta kann vera ein alsamt vaksandi trupulleiki við fólkavøkstri, antibiotikanýtslu og menniskjaligari ávirkan á náttúruna. Alsamt fleiri fólk svimja í sjónum, og umframt hetta eru ætlanir um at bygga eina gøtu frá Betri banka út á Boðanes. Um allir hyljar framvið Betri Banka eru heilsuskaðiligir fyri børn og vaksin at spæla í, og tað at svimja í sjónum er ein heilsuvandi, er tað alneyðugt at fáa hetta viðgjørt sum skjótast, sigur Anni Djurhuus m.a.
Tórshavnar kommuna hevur fíggjað ein part av kanningini og hevur fingið eina frágreiðing, sum byggir á kanningarútslitini, ið eru almannakunngjørd í Frontiers in Environmental Science.
Greinin kann lesast her.
Lesið eisini kunngerð um spillivatn her.